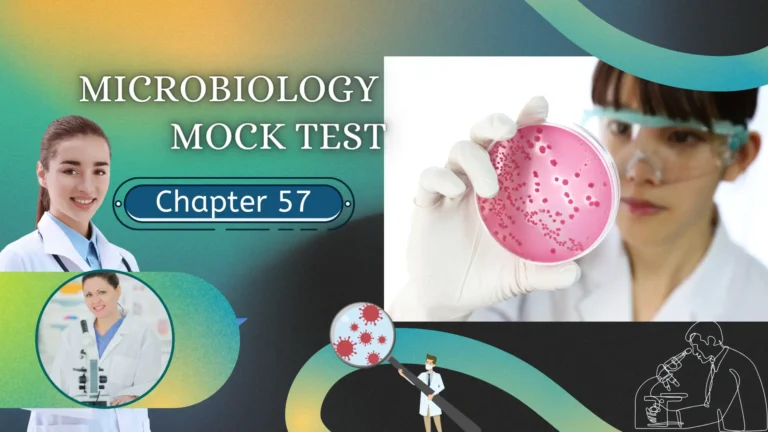

Chapter 71 (Questions No 3501 – 3550) of our Mock Test series is tailored for lab technicians and technologists. It covers crucial topics including anatomy, physiology, microbiology, chemistry, and hematology, offering an in-depth review of essential clinical laboratory sciences. This chapter is a key resource for self-assessment and exam preparation, aiming to enhance your knowledge, refine your test-taking abilities, and boost your confidence for upcoming exams.

3501 to 3550 MCQs Mock Test for Lab Technician and Technologist Exam Preparation
If You like then share this to your friends and other social media.
If You have any question and suggestions then please Contact us Here
Chapter 71 centers on assessing your technical skills within a laboratory environment. This evaluation will gauge your proficiency in accurately interpreting lab results, executing procedures with precision, and efficiently handling laboratory equipment.
A solid grasp of laboratory science fundamentals is crucial for success. To enhance your knowledge, commit to thorough study and hands-on practice. Adhering strictly to safety protocols is also essential.
For optimal preparation, review specialized laboratory textbooks and explore relevant online courses. Utilize sample questions to pinpoint areas requiring improvement and boost your overall readiness.